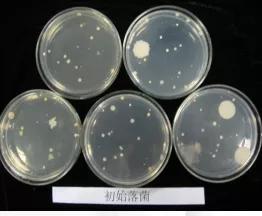
次氯酸水用途，杀菌，保鲜，抗氧化剂百分百安全无刺激灭菌无残留

消毒剂按照其作用的水平:可分为灭菌剂、高效消毒剂、中效消毒剂和低效消毒剂。

灭菌剂
可杀灭一切微生物,使其达到灭菌要求;

高效消毒剂
可杀灭一切细菌繁殖体(包括分枝杆菌)、病毒、真菌及其孢子等,对细菌芽孢也有一定杀灭作用,达到高水平消毒要求;

中效消毒剂
仅可杀灭分枝杆菌、真菌、病毒及细菌繁殖体等微生物;

低效消毒剂
仅可杀灭细菌繁殖体和亲脂病毒。

次氯酸消毒液的优势
消毒剂经历了五代的发展历程。第一代消毒产品的有效成分是氯酸钠,第二代有效成分为对氯间二甲苯酚,第三代的有效成分是单双链复合季铵盐,*四代第**有效成分是二氧化氯,第五代有效成分是次氯酸。目前,第五代产品因其独特优势,在欧美、日本等发达国家得到了广泛的使用。

次氯酸简介
微酸性次氯酸(HClO)作为一种非常有效的环境消毒剂正在迅速崛起。如今,各类病原体对传统消毒剂、抗菌剂和疗法的抗性逐渐增加,使用新的抗感染制剂已成为消除或抑制微生物污染的关键。近年来,次氯酸因其在哺乳动物和多数脊椎动物(包括鱼类)自然防御系统中作为“第一反应者”的作用而被认知。
从广义上而言,次氯酸为感染控制提供了一个新的机遇。此外,电解技术的进步克服了次氯酸原有不稳定性带来的技术挑战,实现了稳定和高纯度次氯酸的大规模生产。新型微酸性次氯酸水具有杀菌能力强、杀菌范围广、无污染、无残留、安全可靠、对人体无毒无害、不刺激皮肤、制取方便等特点。2002年日本将强酸性电解水和微酸性电解水又以次氯酸水的名字被指定成为食品添加剂(杀菌剂)。


生成原理
将含电解液的自来水(原水)输入次氯酸水生成器中的直流电解槽中,在直流电作用下,正负电极间在电解液强化剂参与下,由双向离子交换膜分隔产生下列化学反应并生成次氯酸水。

实验对比
初始落菌

微酸性电解水喷雾1小时落菌
应用领域
在家里、办公室、公车、商场、机房等各类场所,都可以使用,并获得理想的效果。使用后不仅不会在物体表面形成残留和腐蚀, 还能有效地消空气中的异味。氧化电位水应用范围广泛,不像化学消毒剂那样只对特定对象起作用,经实验证明它针对抗酸菌、真菌的杀灭时间为1-3分钟, 对芽孢杆菌的杀灭时间为3-5分钟,对各类微生物均有较强的杀灭作用。所以,自90年代初期该技术在日本诞生后,即被迅速地广泛应用于各种领域。

手部消毒
次氯酸水作为手的清洗消毒液已于1997年通过了日本厚生省的认可,日本一些大医院在采用集中治疗住院楼内各处都配置了自动化次氯酸水供给系统,使医疗工作者采用次氯酸水频繁洗手成为可能。对预防医疗工作者之间的交叉感染取得了显著效果,并且解决了以往使用其他消毒液频繁消毒对手所发生的损害。


皮肤护理
酸性氧化电位水呈弱酸性,分子团小,有极强的渗透力,溶解力和物理活性,含有大量的单质氧,具有很强的杀菌、消毒作用和较强的氧化、收敛作用,它对于皮肤的杀菌、消毒、美容、去皱、增白、保湿、消除皮肤异物都具有独特的作用。 从整个身体的角度来看,*皮人**肤的好坏,10%来自对皮肤的护理,而其余的90%则必须依靠体内的洁净,否则无效或效果不好。斑点、色素沉积、小皱纹等皮肤老化表象,是体内氧化所产生的现象,其并经常饮用电解还原水清除体内污染则是最经济、方便的一种护肤、美容方式。
用微酸性电解水洗脸、洗澡、能迅速渗入毛孔起到收敛作用,经常使用增强肌肤弹性,减少皱纹,使皮肤增白靓丽。具有杀菌抑菌作用,预防青春痘,对晒伤后肌肤护理效果尤佳。


外阴护理
女性的外阴是指生殖器官的外露部分,这里的生理环境具有特殊性,阴道和外阴温暖潮湿,非常适合多种病原生物的生长繁殖,尤其是在外阴部位有富含蛋白的阴道分泌物,形成了病原生物繁殖的温床。此外,阴道内的PH约为4,如果经常使用碱性过高或者具有强氧化作用的洗涤用品清洁外阴部,就会破坏阴道的酸性环境,导致女性自我保护功能的降低甚至丧失,外界的病源生物就会趁虚而入,造成感染致病。
微酸性次氯酸水pH值是4-7,不会破坏阴道的酸性环境,且具有杀菌能力强、杀菌范围广、无污染、无残留、安全可靠、无毒无害、不刺激皮肤及黏膜等特点,因此可用于女性外阴的日常清洗护理,预防妇科炎症的发生。

眼睛护理
国外团队已经开始使用次氯酸治疗Boston 1 型人工角膜术后的真菌感染,取得良好效果 。聚维酮碘结膜囊消毒,可显著减少白内障术后感染并发症,研究表明,使用次氯酸水溶液消毒,也可有效杀灭结膜囊细菌,并减少角膜上皮损伤等聚维酮碘相关眼部并发症的发生。在眼部用药安全性上,动物实验表明,使用浓度为0. 01%、0. 03%、0. 1%的次氯酸水溶液局部滴眼,均未出现眼部刺激症状 。
在美国,已经有不少以次氯酸(HClO)为主要成分的眼科护理产品。

创口清洁护理



口腔清洁
目前牙医治疗用水中充满了细菌,已被各种致病微生物和非致病微生物严重污染,导致牙科病人在看病时很容易受到交叉感染,甚至感染乙肝、艾滋等病毒。
口腔行业正在探索用微酸性次氯酸溶液消毒的方法。根据各项专业机构的检测数据表明,微酸性次氯酸溶液具有很强的杀菌和消毒效果,无论直接用于口腔中清洁牙齿,或用于牙科设备水管道内的杀菌,效果显著。且次氯酸消毒液是一种对人体皮肤、粘膜无毒(可以漱口)无刺激、无致敏(直接给伤口消毒无疼痛感),对环境无污染的环保型消毒液,可以安全放心的使用。

母婴清洁防护
微酸性次氯酸水100%安全且无刺激性。微酸性次氯酸是PH值与人体皮肤一致,不会刺激皮肤的,无毒、对人体无害,杀菌后可降解成盐和水,无残留、不刺激皮肤,足够安全,非常适合婴儿奶嘴等婴儿产品使用。原理是因为人体本身也会产生次氯酸,当细菌侵入人体内或表皮受损时,白血球会开始作用抵抗外来细菌与病毒,此时白血球就会分泌次氯酸,专门破坏细菌与病毒的细胞壁,让细菌与病毒无法生存,由于与人体机能相同,就是所谓的生物相容性,不具伤害性,是孕妇幼儿使用的很安全的消毒产品。可以解决小孩的尿布疹和预防各种妇科疾病,无污染、无残留、无毒副作用。

日常家用
微酸性次氯酸水作为消毒剂用于家庭杀菌消毒,可用于菜板、抹布、餐具、家具的消毒,也可以用于宠物、衣物、玩具,玻璃、地板、墙壁、空气的消毒和杀菌以及厕所的消毒、除异味。




使用方法
